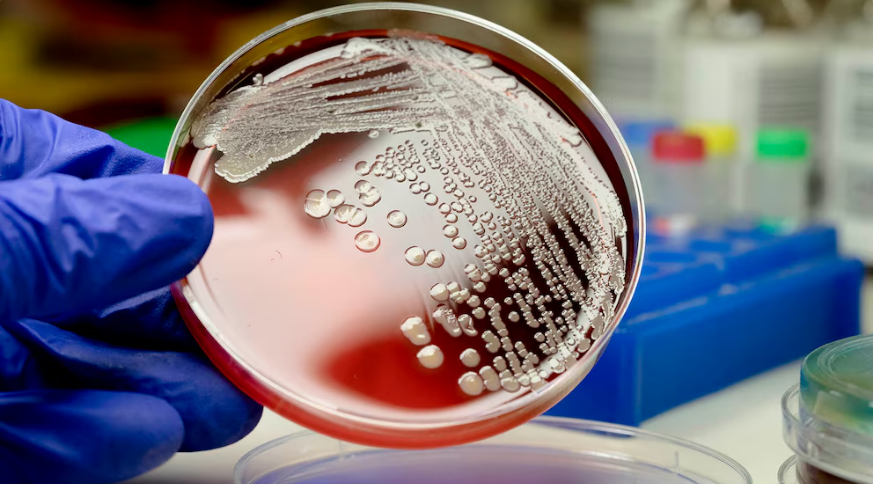

La Secretaría de Salud advierte sobre la gravedad de la meningitis y la importancia de la vacunación.
Yucatán (Marcrix, Noticias).- Yucatán enfrenta un incremento en los casos de meningitis, una enfermedad que puede ser mortal en menos de 24 horas. Este alarmante aumento se destaca en el contexto del Día Mundial de la Meningitis, celebrado este 5 de octubre, con el objetivo de erradicar esta enfermedad a nivel global para 2030.
La Secretaría de Salud de México (SSA) emitió una alerta sobre la necesidad de controlar la fiebre para prevenir secuelas asociadas a convulsiones.
Aunque este año no se han reportado casos de meningitis meningocócica en Yucatán ni en los estados vecinos de Campeche y Quintana Roo, la situación es preocupante a nivel nacional.
En 2024, se han registrado 24 casos de meningitis, lo que representa un aumento del 20% en comparación con el año anterior. Jalisco se posiciona como el estado con mayor incidencia, reportando 47 casos.
En Yucatán, hasta el 21 de septiembre de 2024, se han documentado seis casos de meningitis tuberculosa, un incremento de uno respecto al mismo periodo del año anterior.
En total, 420 personas han contraído meningitis tuberculosa en 30 estados de México, con la Ciudad de México liderando los reportes con 11 casos.
La SSA destaca la importancia de la vacunación como medida preventiva. Se recomienda aplicar las siguientes vacunas: BCG al nacer, la pentavalente a los dos, cuatro, seis y 18 meses, y la vacuna contra neumococo a los dos, cuatro y 12 meses de edad.
Estas vacunas son cruciales para proteger a la población de las bacterias causantes de la enfermedad.
La meningitis, que se define como la inflamación de las meninges que envuelven el cerebro y la médula espinal, es una condición que puede afectar a cualquier persona, en cualquier lugar y en cualquier momento.
En Yucatán, se registró la muerte de un bebé menor de un año por meningitis en 2022, lo que resalta la urgencia de la atención médica adecuada y la prevención a través de la vacunación. Las cifras del 2023 se darán a conocer a finales de este mes, lo que permitirá una mejor evaluación de la situación en el estado.